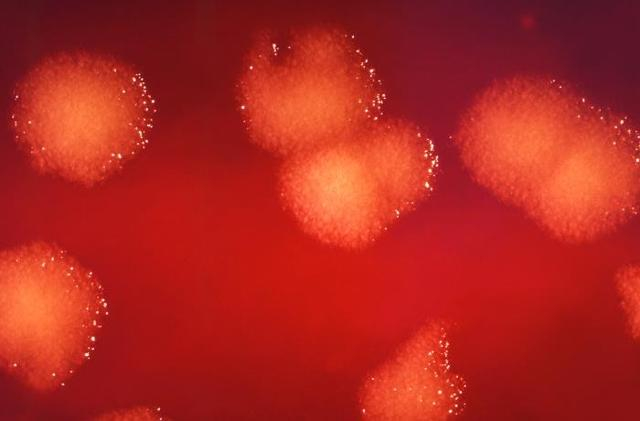
在2.5倍显微镜下，近距离观察培养皿上培养的炭疽芽孢杆菌菌落，图片来自于网络

原标题:炭疽病来自病牛羊,那牛羊肉还能吃吗? 来源:上观新闻

天气转凉,不少家庭开始购买牛羊肉。但今年8月,北京报告了1例外地来京就诊肺炭疽病例,随后,山西省又发生疑似皮肤炭疽疫情。提到炭疽不少人会想到肉制品,炭疽是什么?来自哪里?怎么预防?让疾控君带您了解。
“生命力”顽强的致病细菌
它曾经是上个世纪最可怕的生化武器之一。炭疽杆菌可以在自然界土壤中长期稳定存在,虽然细菌繁殖体的抵抗力与一般细菌无异,常规浓度的消毒剂也能迅速杀灭,但一旦菌体接触空气,即可产生特殊成分——芽孢,它能在自然条件或在腌渍的肉中长期生存,在土壤中可存活数十年。食草动物通常会在吃草时接触到它们的孢子而被感染,人类经皮肤、口或吸入途径接触了感染牲畜的肉类、毛皮,或被患病牲畜的血液和其他排出物所污染的物品后,也会被感染。
在2.5倍显微镜下,近距离观察培养皿上培养的炭疽芽孢杆菌菌落,图片来自于网络
人兽共患炭疽
人群对炭疽普遍易感。其中,动物饲养、屠宰、制品加工、销售以及兽医等与牛羊、动物接触频繁的人员为高危人群。因此患者多见于牧区,呈地方性散发流行。同时炭疽病在全年均有可能发病。
感染途径:牛羊在食草时接触到芽孢而感染炭疽,人类与病牛羊接触而被炭疽芽孢所感染,是近些来年常有小规模炭疽疫情暴发的主要原因之一。
当炭疽芽孢进入机体后,病原菌可形成保护性的荚膜,并在局部繁殖,产生大量毒素,导致脏器和组织出血性浸润、坏死,严重时会引起炭疽败血症和脑膜炎。
与感染途径相对应,人感染炭疽后的临床表现大致可分为三种类型:皮肤炭疽、肺炭疽和肠炭疽。其中,皮肤炭疽最为常见,占全部病例的95%以上。
皮肤炭疽病变主要表现为局部皮肤的水肿、斑疹或丘疹、水疱、溃疡和特征性的黑痂。疼痛不明显,稍有痒感,无脓肿形成。及时治疗病死率较低,小于1%。
芽孢如被人体吸入可导致肺炭疽,初期症状与感冒相类似,表现为轻微的上呼吸道感染,低热、干咳。疾病发展病情可急骤加重,表现为高热、寒战、呼吸急促、发绀、咯血样痰、心率增速,颈、胸部可有皮下水肿。患者病情大多危重,常并发败血症和感染性休克甚至死亡。
肠炭疽主要是由于进食带菌肉类所致,以急性肠道感染为特征。主要症状为恶心、厌食、呕吐和发热,重者腹痛、吐血和有严重的水样便。肠炭疽导致的死亡病例占到25%-60%。

皮肤炭疽感染所引起的病灶,图片来自于网络
做好防护、及早治疗
由于一般人接触到炭疽的概率很小,目前虽然已有炭疽减毒疫苗可用,但并未进行大规模人群接种。对于从事畜牧业、畜产品收购、加工、屠宰业等工作人员和疫区人群,可考虑每年定期接种疫苗,同时在与易感动物接触或进行相关操作时,应佩戴手套、口罩等防护装备,做好自身防护。对于易感动物的养殖、运输、屠宰等相关流程均须严格执行落实卫生消毒等动物防疫措施。发生炭疽疫情时,对于感染疫区的动物一般都采取病死动物严格捕杀并焚烧、易感动物高密度免疫接种、封锁疫区等防控手段,阻断疾病传播。
已感染炭疽的病人关键在于早期发现、早期治疗,任何延误都可能导致严重后果。目前临床上抗生素治疗对于炭疽病人较为有效,因此,在一般对症治疗的基础上进行病原学治疗,炭疽杆菌对青霉素、氨基糖苷类抗生素以及氯霉素等都具有高度敏感性。
敲黑板
当发现牛、羊等动物突然死亡,要做到不接触、不宰杀、不食用、不买卖,立即报告当地农业畜牧部门,由该部门来进行处置。只要是通过正规渠道购买肉制品,烹饪时煮熟煮透,还是可以放心大快朵颐哒!
参考来源:
[1] 中国疾病预防控制中心 http://www.chinacdc.cn
[2] 世界卫生组织 http://www.who.int/zh/
[3] 美国疾病预防控制中心公共健康素材库 phil.cdc.gov/
上海市科委科普项目资助
项目编号:20DZ2312100
供 稿:崔晓娴
编 辑:吴兆宇


